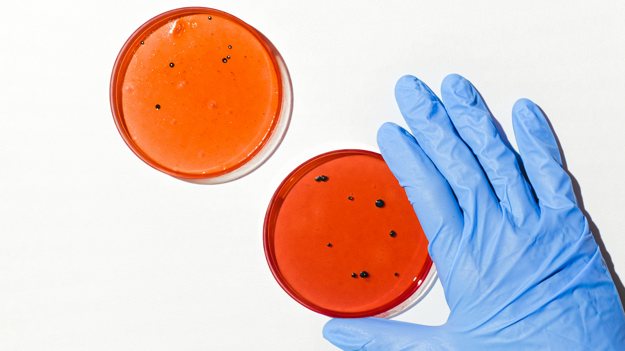

DISTRETTO BIOTECNOLOGICO
di Benevento
Un luogo di intelligenza dove la ricerca incontra l'azienda e fa da cerniera
La città che cambia, la proposta di Confindustria Benevento per il distretto biotecnologico
guarda le nostre interviste
Migliorare la salute e il benessere costituisce l'obiettivo principale del Distretto Biotecnologico di Benevento.
Miriamo a prevenire e curare le malattie, consentendo a tutte le persone di vivere una vita più lunga e di godere di un benessere ottimale.


NUOVE ADESIONI:
CeRICT
Il CeRICT, con la sua vasta esperienza e competenza nel campo delle ICT, conferisce un importante sostegno all'idea del distretto biotecnologico, contribuendo così all'avanzamento e alla sinergia delle iniziative nel contesto della ricerca e dell'innovazione.
Il CeRICT conta tra i suoi soci istituzioni di spicco come l'Università degli Studi di Napoli Federico II, l'Università degli Studi del Sannio, l'Università degli Studi di Salerno, l'Università degli Studi della Campania Luigi Vanvitelli, l'Università degli Studi di Napoli Parthenope, il Consiglio Nazionale delle Ricerche, l'Università degli Studi di Napoli L'Orientale, l'Università degli Studi Suor Orsola Benincasa di Napoli, il Consorzio Interuniversitario Nazionale per l’Informatica, e la Fondazione Pascale.

Il Distretto Biotecnologico si focalizza su aree di ricerca interdisciplinari: Genomica, Neurogenomica, Biologia Strutturale, Biologia Computazionale e Health Data Science.
Attraverso uno studio globale e interdisciplinare della biologia umana, la nostra ricerca si propone di comprendere i meccanismi alla base delle diverse patologie. Sfruttiamo gli avanzamenti biologici dell'ultimo decennio e l'ampia disponibilità di dati biologici, clinici e socio-economici per migliorare la qualità della vita.

Un Futuro di Salute e Innovazione a Benevento
Cosa Rende la Nostra Idea Unica:
- Innovazione Senza Limiti: Il nostro centro sarà un laboratorio vivente, sperimentando e innovando in tempo reale per affrontare le sfide mediche più pressanti.
- Focus sulla Collaborazione: Collaboreremo con istituzioni e aziende, connettendo esperti medici con menti brillanti della biologia computazionale per risultati che vanno oltre le aspettative.
- Impatto Tangibile: La biologia computazionale non è solo teoria; è la chiave per soluzioni pratiche e avanzamenti concreti nel trattamento delle malattie.
Immaginate un futuro in cui la medicina è guidata da algoritmi intelligenti, in cui l'IA collabora strettamente con le brillanti menti delle università locali. Questa è la visione del nostro progetto.

La sinergia con le Università locali, in particolare l'Università degli Studi del Sannio e l'Università degli Studi del Molise, è il fondamento stesso della nostra iniziativa nel campo medico. L'eccellenza e l'esperienza che queste istituzioni portano con sé sono di valore inestimabile per il progresso delle nostre ricerche.

Le brillanti menti accademiche delle nostre università partner fungono da guida e fonte di ispirazione, plasmando il percorso della nostra indagine scientifica. La collaborazione con l'Università del Sannio e l'Università del Molise non è solo una connessione formale, ma un legame profondo con il sapere locale, che arricchisce e approfondisce il nostro impegno nella comprensione delle malattie e nell'innovazione medica.

Questa collaborazione multidisciplinare sarà la chiave per il successo del nostro progetto, facilitata dalla vicinanza strategica con l'Ospedale Sacro Cuore di Gesù - Fatebenefratelli di Benevento.
L'Oncology Network Center (ONC), la prima rete oncologica del Sud Italia dedicata esclusivamente alla ricerca contro il cancro in tutte le sue sfaccettature, sarà parte integrante del progetto.
UNISCITI A NOI
Entra nel Futuro della Medicina
Se sei un professionista nel campo medico, biologico, o un ricercatore appassionato, questa è la tua opportunità per contribuire al futuro della medicina. Il nostro campus biomedicale offre progetti pionieristici, mettendo la ricerca direttamente a contatto con i pazienti. Invia il tuo curriculum a info@distrettobiotechnologicobn.it e fai parte della nostra missione di innovazione medica.
Saremo lieti di parlare con te e discutere possibili collaborazioni.

UNISCITI A NOI
Guidiamo l'Innovazione Biomedicale
Se rappresenti un'azienda impegnata nell'innovazione biomedicale, collabora con noi per creare un hub dedicato alla medicina del futuro. Il nostro progetto mira a promuovere la collaborazione tra mondo accademico, industria e governo locale. Invia la tua dichiarazione d’interesse a info@distrettobiotechnologicobn.it e contribuisci alla crescita del settore biomedicale.
Saremo lieti di parlare con te e discutere possibili collaborazioni.
Benevento, con la sua ricca storia e la sua comunità dinamica, è pronta a diventare un faro dell'innovazione biomedica. Collaborare con le istituzioni accademiche come Uni Sannio e Uni Mol è fondamentale per plasmare un ambiente in cui l'IA può contribuire in modo tangibile alla ricerca medica. Questo progetto non solo apre nuove opportunità di sviluppo per la nostra città, ma promuove anche una collaborazione fruttuosa tra settori chiave.
